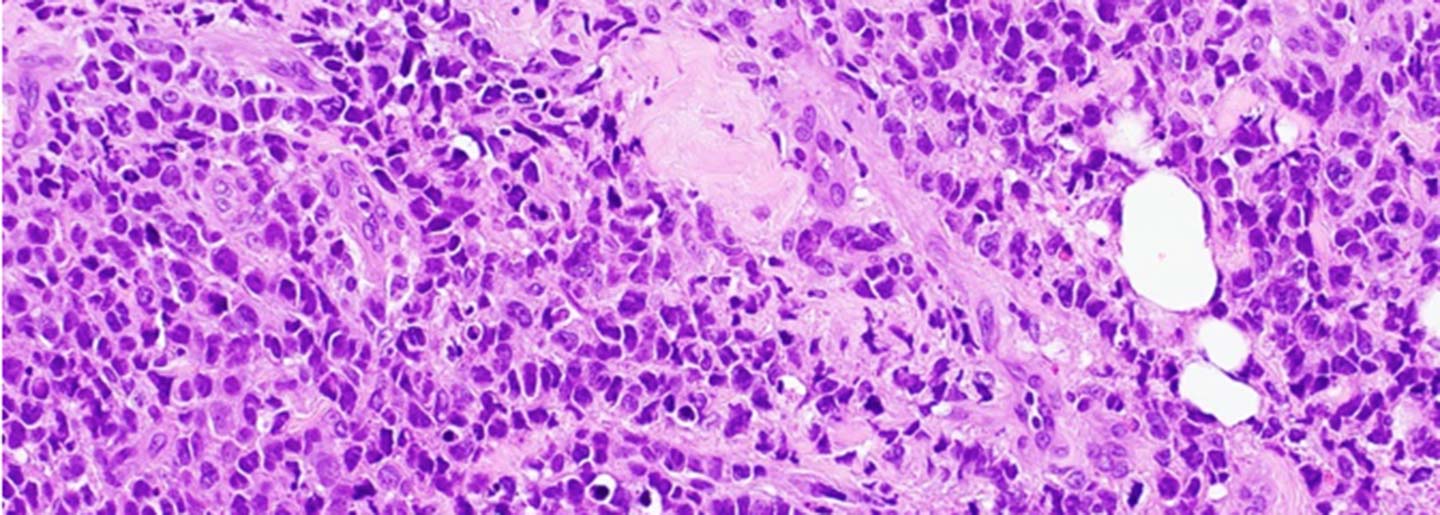

Moffitt Researchers Identify Key Genomic Alterations and Potential Therapeutic Vulnerabilities in Transformed Cutaneous T-Cell Lymphoma
TAMPA, Fla. — Cutaneous T-cell lymphoma (CTCL) is an incurable, rare cancer of skin-homing T cells that is highly disfiguring and lethal at advanced stages. The most common form of CTCL, mycosis fungoides, is characterized by a cutaneous patch, plaque and/or tumor lesions. Another form, Sezary syndrome, is the leukemic variant of CTCL with circulating malignant T cells in the blood. Large cell transformation occurs in a subset of mycosis fungoides and Sezary patients heralding immediate transition to an aggressive large cell lymphoma. However, given the rare nature of CTCL, gathering adequate tissue specimens to investigate the tumor microenvironment at large cell transformation has been a significant roadblock to potential therapeutic advances.
In a new article published in Cancer Discovery, a journal of the American Association for Cancer Research, Moffitt Cancer Center researchers shared a comprehensive multiomics study from a rare cohort of 56 patients with transformed CTCL and identified several genomic alterations and oncogenic programs that may be potential novel therapeutic targets.
“While cancer death rates have significantly declined for many common cancers in the past decade, there is a sobering underrepresentation of this success in rare cancers, such as CTCL, particularly in the vulnerable racial minority groups,” said study senior author Pei-Ling Chen, M.D., Ph.D., associate member of the Pathology and Cutaneous Oncology Departments and member of the Moffitt Cutaneous Lymphoma Multidisciplinary Clinic, one of the largest CTCL referral centers in the U.S.
Moffitt researchers, in collaboration with scientists at MD Anderson Cancer Center, performed multiomics profiling of 70 biopsies and 16 fresh tissue specimens from patients with transformed CTCL and investigated the tumor ecosystem using integrative approaches spanning whole exome sequencing, single-cell RNAseq and immune profiling by single-cell V(D)J sequencing and multiplex immunofluorescence studies. The researchers discovered that the genomic landscape of transformed CTCL is characterized by a high tumor mutation burden and UV mutation signatures that are prognostic for survival. Importantly, transformed CTCL samples from Black/African American patients showed significantly lower contribution of UV signatures and enrichment of mutation signatures that are associated with defective DNA mismatch repair. The research team also identified several recurrently mutated pathways and exome-based driver events in transformed CTCL and showed dissimilarity in the genomic landscape of transformed T cells in skin versus leukemic T cells in blood, revealing opportunities to exploit differential or synergistic therapeutic vulnerabilities in the two body compartments at advanced stage disease.
To interrogate the transformed CTCL tumor ecosystem at single-cell resolution, the researchers then profiled 34,912 cells from 16 fresh tissue biopsies by single-cell RNA and V(D)J sequencing. The research team identified the core oncogenic programs that malignant T cells exploit at large cell transformation, including metabolic reprogramming toward oxidative phosphorylation, cellular plasticity, upregulation of MYC, E2F and macrophage migration inhibitory factor activities, and downregulation of MHC-I suggestive of immune surveillance escape. These signatures were further validated by pharmacologic perturbation studies using novel small molecule inhibitors of oxidative phosphorylation and MYC and multiplex immunofluorescence imaging.
“While further validation in larger cohorts and pre-clinical models are needed, our investigation provides a key resource to the community with the largest collection of transformed CTCL samples studied to date, the first comprehensive compendium of genomic alterations at large cell transformation, a blueprint for dissecting the T-cell lymphoma tumor microenvironment at single-cell resolution and identifies potential prognostic signatures and novel therapeutic targets in transformed CTCL. We anticipate results from this study can be extrapolated to other T-cell lymphomas and will help usher novel immunotherapeutic strategies to combat this currently incurable cancer,” said Chen.
While racial disparity is well-known to exist in CTCL, with Black and African American patients showing worse clinical outcomes, potential biological factors underlying this disparity are poorly understood. The researchers hope that their findings can provide insights into potential genomic correlate of this disparity. Future studies involving larger sample size from the vulnerable population and research into their tumor microenvironment for predictive biomarkers and novel therapeutic targets will hopefully help reduce racial disparity in CTCL.
This study was supported by the Moffitt Foundation, Moffitt Clinical Science Fund, Miles for Moffitt, Total Cancer Care, the Donald A. Adam Melanoma & Skin Cancer Center of Excellence and the National Cancer Institute (P30-CA076292, R01CA240434).
About Moffitt Cancer Center
Moffitt is dedicated to one lifesaving mission: to contribute to the prevention and cure of cancer. The Tampa-based facility is one of only 52 National Cancer Institute-designated Comprehensive Cancer Centers, a distinction that recognizes Moffitt’s scientific excellence, multidisciplinary research, and robust training and education. Moffitt’s expert nursing staff is recognized by the American Nurses Credentialing Center with Magnet® status, its highest distinction. With more than 7,500 team members, Moffitt has an economic impact in the state of $2.4 billion. For more information, call 1-888-MOFFITT (1-888-663-3488), visit MOFFITT.org, and follow the momentum on Facebook, Twitter, Instagram and YouTube.

